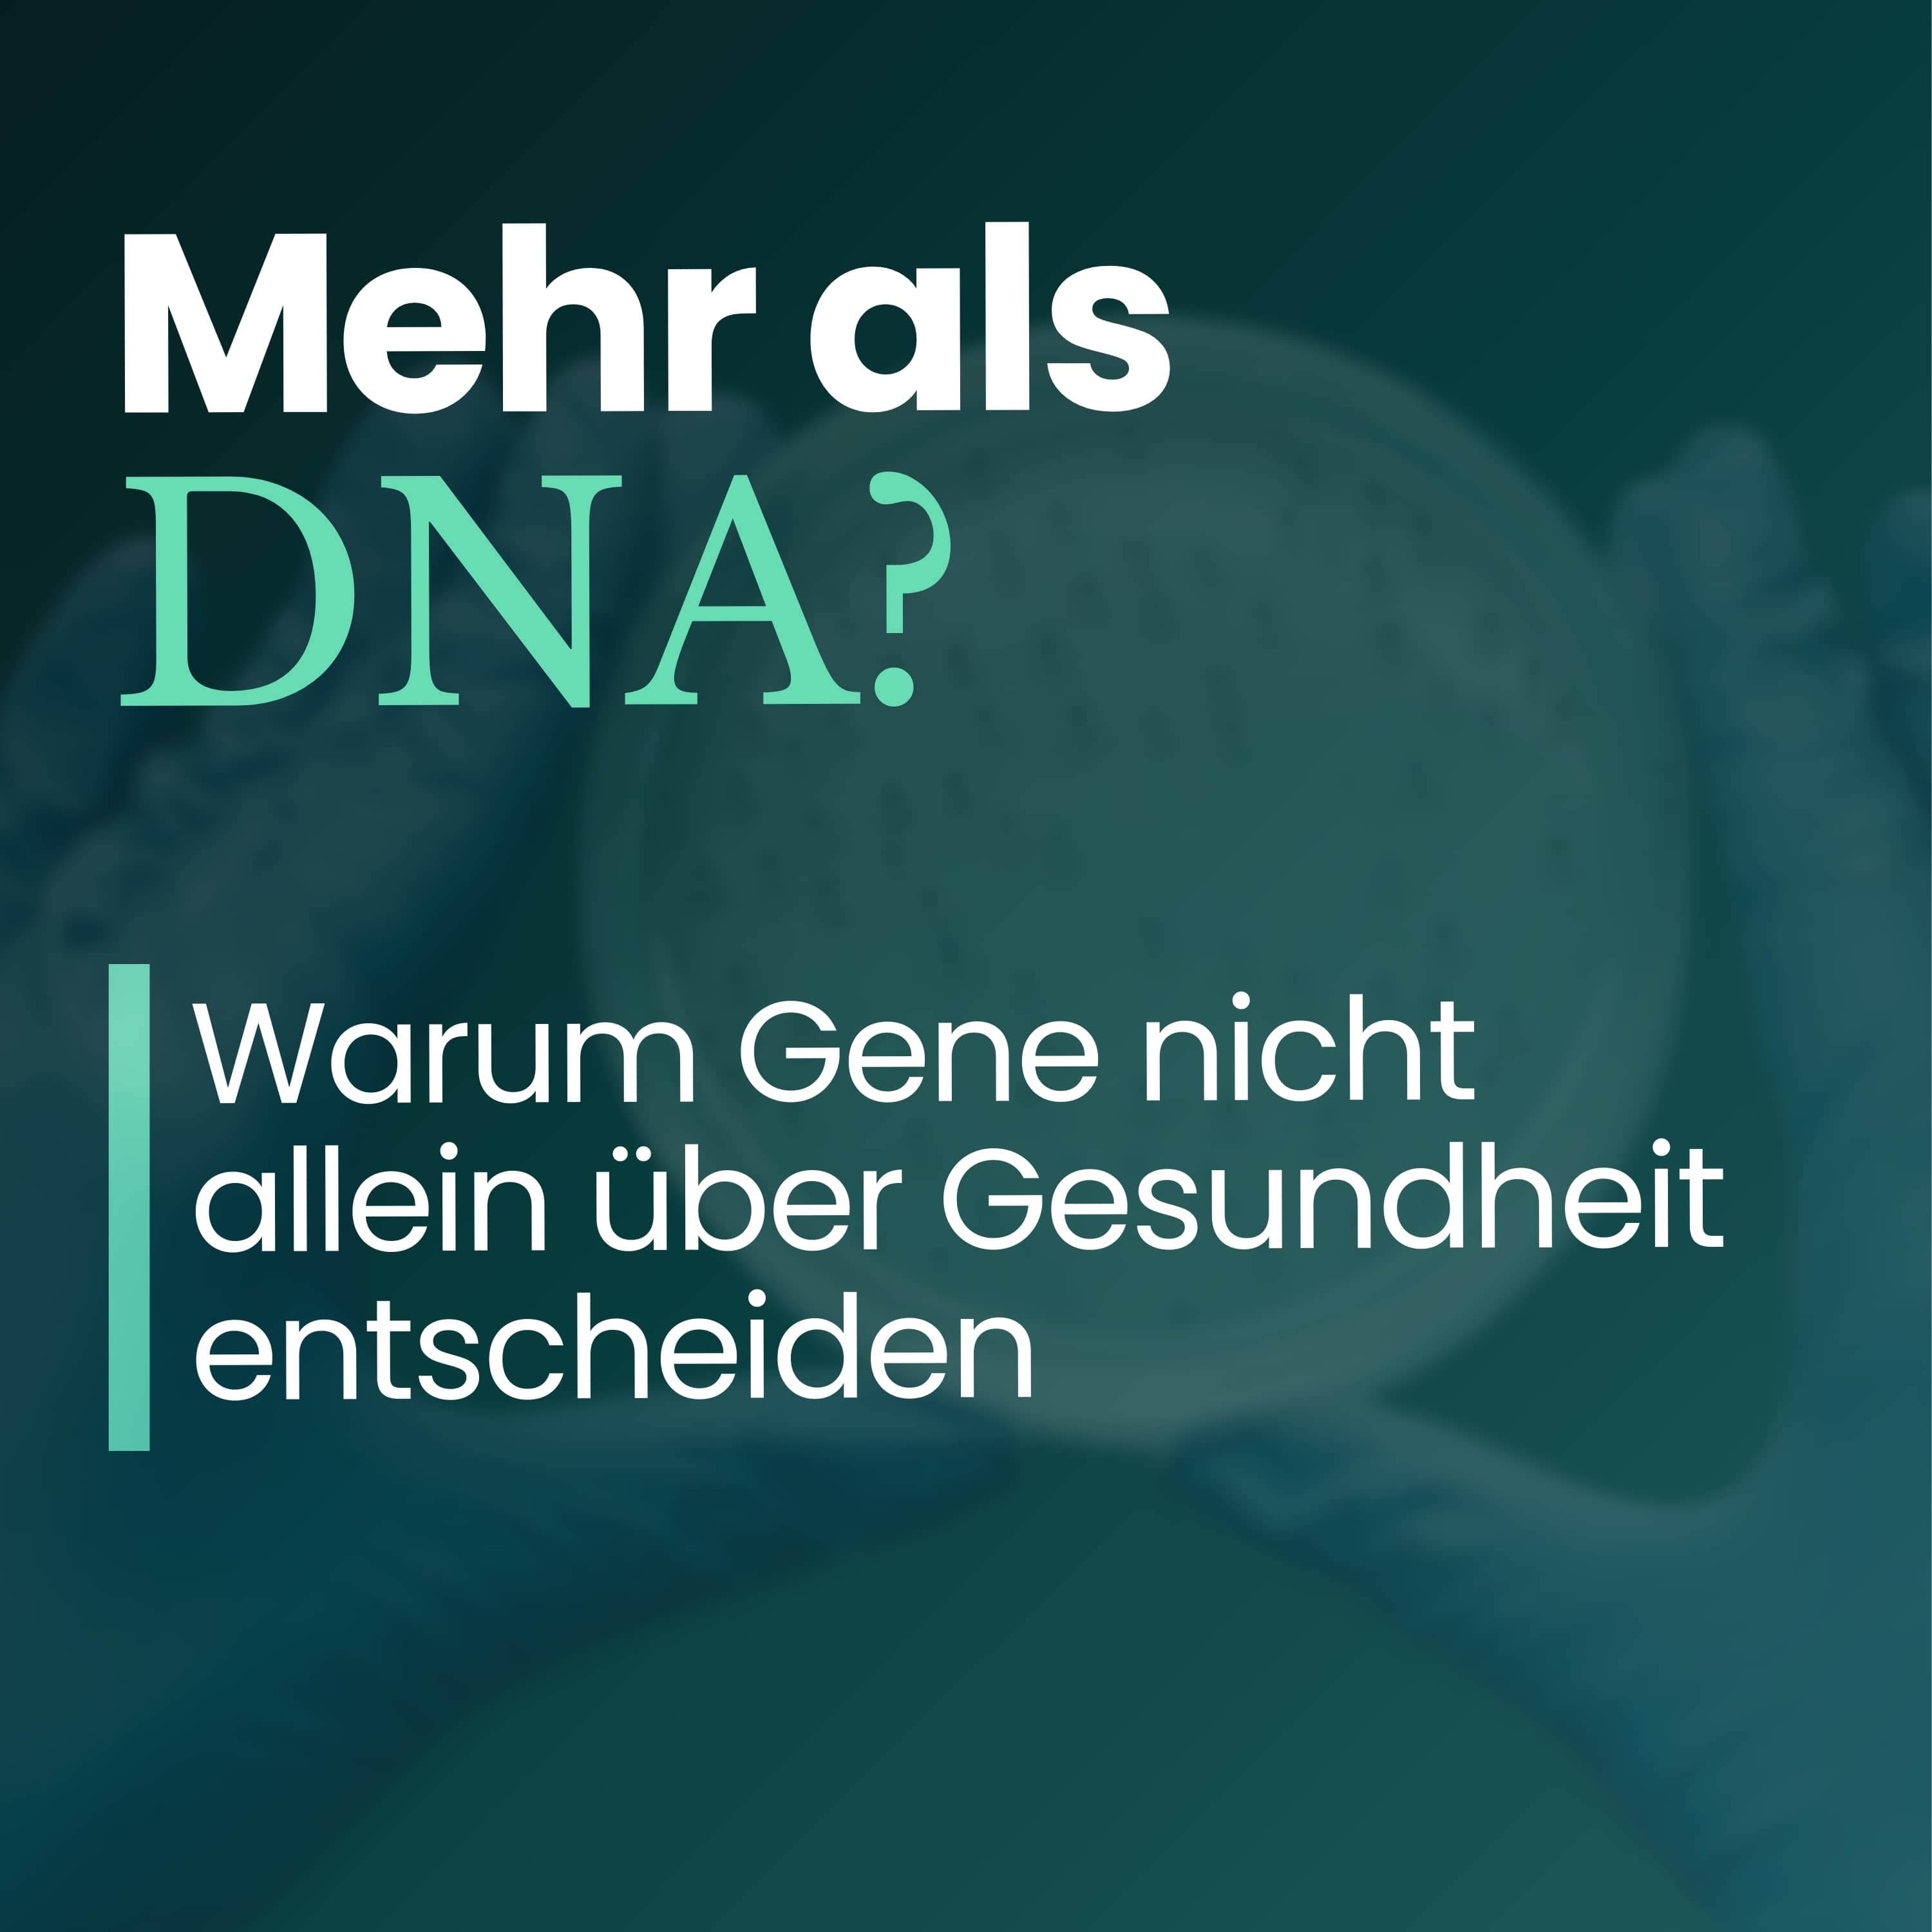
Epigenetik: Sind unsere Gene wirklich unser Schicksal? | Teil 1 Epigenetik: Sind unsere Gene wirklich unser Schicksal? | Teil 1

Discover
Schulmedizin trifft Naturheilkunde
Schulmedizin trifft Naturheilkunde
Author: KfN - Krankenhaus für Naturheilweisen
Subscribed: 1Played: 10Subscribe
Share
© KfN - Krankenhaus für Naturheilweisen
Description
Die beste Medizin aus beiden Welten - wissenschaftlich fundiert, praktisch erklärt.
Chronische Schmerzen, Schlafstörungen, Entzündungen, 45% aller Deutschen leben mit chronischen Erkrankungen. Doch zwischen Schulmedizin und Naturheilkunde fühlen sich viele verloren. Genau hier setzt dieser Podcast an.
Robert Schmidt, Chefarzt der größten Klinik für integrative Medizin in Deutschland, zeigt Ihnen den dritten Weg: Evidenzbasierte integrative Medizin. Mit über 20 Jahren Praxiserfahrung und 3.000 behandelten Patienten pro Jahr teilt er, was WIRKLICH funktioniert.
Was Sie erwartet:
Studien statt Stories: Zu jedem Thema 2-3 aktuelle wissenschaftliche Studien
Praxiserfahrung: Erkenntnisse aus 110 Betten und tausenden erfolgreichen Behandlungen
Klartext ohne Dogma: Weder "nur Pillen" noch "Chemie ist Gift" – sondern das Beste aus beiden Welten
Alltagstauglich: Konkrete Protokolle und Handlungsempfehlungen für Ihre Gesundheit
Ob Diabetes Typ 2, chronische Erschöpfung, Rheuma oder Silent Inflammation wir erklären die wissenschaftlichen Mechanismen verständlich und zeigt Ihnen, wie Sie selbst aktiv werden können.
Jeden Mittwoch eine neue Episode mit echten Patientengeschichten, Expertenrunden und wissenschaftlichen Insights.
Viel Spaß beim Zuhören.
Disclaimer: Dieser Podcast ersetzt keine ärztliche Behandlung. Besprechen Sie Therapieänderungen immer mit Ihrem Arzt. Setzen Sie Medikamente niemals eigenmächtig ab.
Chronische Schmerzen, Schlafstörungen, Entzündungen, 45% aller Deutschen leben mit chronischen Erkrankungen. Doch zwischen Schulmedizin und Naturheilkunde fühlen sich viele verloren. Genau hier setzt dieser Podcast an.
Robert Schmidt, Chefarzt der größten Klinik für integrative Medizin in Deutschland, zeigt Ihnen den dritten Weg: Evidenzbasierte integrative Medizin. Mit über 20 Jahren Praxiserfahrung und 3.000 behandelten Patienten pro Jahr teilt er, was WIRKLICH funktioniert.
Was Sie erwartet:
Studien statt Stories: Zu jedem Thema 2-3 aktuelle wissenschaftliche Studien
Praxiserfahrung: Erkenntnisse aus 110 Betten und tausenden erfolgreichen Behandlungen
Klartext ohne Dogma: Weder "nur Pillen" noch "Chemie ist Gift" – sondern das Beste aus beiden Welten
Alltagstauglich: Konkrete Protokolle und Handlungsempfehlungen für Ihre Gesundheit
Ob Diabetes Typ 2, chronische Erschöpfung, Rheuma oder Silent Inflammation wir erklären die wissenschaftlichen Mechanismen verständlich und zeigt Ihnen, wie Sie selbst aktiv werden können.
Jeden Mittwoch eine neue Episode mit echten Patientengeschichten, Expertenrunden und wissenschaftlichen Insights.
Viel Spaß beim Zuhören.
Disclaimer: Dieser Podcast ersetzt keine ärztliche Behandlung. Besprechen Sie Therapieänderungen immer mit Ihrem Arzt. Setzen Sie Medikamente niemals eigenmächtig ab.
15 Episodes
Reverse
Fibromyalgie ist eine Erkrankung, die sich nicht eindeutig messen oder bildlich darstellen lässt.
Für Betroffene bedeutet das häufig einen langen Weg mit vielen Untersuchungen, Unsicherheit und dem Gefühl, nicht ernst genommen zu werden..
Eine Diagnose kann entlasten. Sie kann aber auch neue Fragen aufwerfen. Was bedeutet sie wirklich? Was verändert sie und was nicht?
Worum geht’s in dieser Folge?
- Warum Fibromyalgie schwer eindeutig zu erfassen ist
- Welche Rolle strukturierte Abklärung und ärztliche Erfahrung spielen
- Welche Labor- und Untersuchungsbefunde sinnvoll sind
- Warum andere Erkrankungen ausgeschlossen werden müssen
- Fibromyalgie als zentrale Wahrnehmungsstörung
- Warum Fibromyalgie chronisch verläuft, aber behandelbar ist
Mehr über KfN - Krankenhaus für Naturheilweisen:
Webseite: https://www.krankenhaus-naturheilweisen.de/
Instagram: https://www.instagram.com/kfn_naturheilweisen/
LinkedIn: https://www.linkedin.com/company/krankenhaus-fuer-naturheilweisen
Disclaimer (medizinischer Hinweis):
Die bereitgestellten Inhalte dienen ausschließlich der allgemeinen Information und ersetzen keine ärztliche Untersuchung, Diagnose oder Behandlung. Treffen Sie keine gesundheitlichen Entscheidungen allein auf Grundlage dieser Aussagen. Wenn Sie Beschwerden haben oder eine Behandlung in Erwägung ziehen, besprechen Sie dies immer persönlich mit einer Ärztin, einem Arzt oder einer anderen qualifizierten medizinischen Fachperson.
Kapitel:
00:00 Intro
01:36 Fibromyalgie als Ausschlussdiagnose
02:15 Fragebogen Score und Begleitsymptome
03:20 Anamnese körperliche Untersuchung Laborwerte
04:30 Vitamin D und differenzierte Abklärung
05:11 Arbeitsdiagnose statt jahrelanger Suche
06:04 Aufklärung Ängste und Prognose
08:09 Erster Schritt nach der Diagnose Education
09:00 Bewegung als zentrale Basistherapie
10:20 Wärme Sauna und Ganzkörperhyperthermie
13:35 Chronischer Verlauf ohne Heilung
15:31 Medikamente Antidepressiva und Grenzen
17:00 Naturheilkundliche Ansätze Entzündung Darm Mitochondrien
19:44 Fasten Intervallfasten und Ernährung
23:33 Selbsthilfe Bewegung Wärme Entspannung
29:35 Stressreduktion vegetatives Nervensystem
#podcast #gesundheit #kfn #krankenhaus #Fibromyalgie #behandlungsmöglichkeiten #untersuchungen #befunde #hilfe
Alter lässt sich nicht allein über das Geburtsdatum beschreiben.
Menschen gleichen Alters unterscheiden sich oft deutlich in Belastbarkeit, Regeneration und funktioneller Leistungsfähigkeit.
Biologisches Altern zeigt sich in vielen Bereichen: in Muskelkraft, Ausdauer, Zellregeneration und in der Art, wie Gene abgelesen werden. Diese Faktoren lassen sich heute zunehmend messen und vergleichen, mit Methoden, die über das chronologische Alter hinausgehen.
Worum geht’s in dieser Folge?
- Chronologisches Alter vs. biologisches Alter
- Wie sich der Funktionszustand des Körpers beurteilen lässt
- Bedeutung von Kraft, Ausdauer und Muskelmasse
- Epigenetik und altersabhängige Muster
- Einfluss von Bewegung, Ernährung und Schlaf
- Kalorienrestriktion und Intervallfasten
- Wo Selbstoptimierung sinnvoll ist und wo nicht
Mehr über KfN - Krankenhaus für Naturheilweisen:
Webseite: https://www.krankenhaus-naturheilweisen.de/
Instagram: https://www.instagram.com/kfn_naturheilweisen/
LinkedIn: https://www.linkedin.com/company/krankenhaus-fuer-naturheilweisen
Disclaimer (medizinischer Hinweis):
Die bereitgestellten Inhalte dienen ausschließlich der allgemeinen Information und ersetzen keine ärztliche Untersuchung, Diagnose oder Behandlung. Treffen Sie keine gesundheitlichen Entscheidungen allein auf Grundlage dieser Aussagen. Wenn Sie Beschwerden haben oder eine Behandlung in Erwägung ziehen, besprechen Sie dies immer persönlich mit einer Ärztin, einem Arzt oder einer anderen qualifizierten medizinischen Fachperson.
#podcast #gesundheit #kfn #krankenhaus #longivity #langesleben #altern #gesundaltern #verlängern #medizin #forschung #bedeutung
Chronische Schmerzen ohne klare Befunde stellen Betroffene und Ärzte oft vor große Probleme.
Gelenkschmerzen, Muskeln tun weh, die Belastbarkeit sinkt und dennoch bleiben Laborwerte, Bildgebung und Untersuchungen unauffällig.
Fibromyalgie gehört zu den Erkrankungen, die lange nicht erkannt werden.
Viele Betroffene haben bereits einen langen Weg hinter sich, bevor es überhaupt einen Namen für ihre Beschwerden gibt.
Worum geht’s in dieser Folge?’
- Was Fibromyalgie ist und wie häufig sie vorkommt
- Warum Frauen deutlich häufiger betroffen sind als Männer
- Typische Symptome von Fibromyalgie
- Warum bildgebende Verfahren und Laborwerte oft unauffällig bleiben
- Warum die Diagnose häufig erst nach Jahren gestellt wird
- Abgrenzung zu rheumatischen und entzündlichen Erkrankungen
Mehr über KfN - Krankenhaus für Naturheilweisen:
Webseite: https://www.krankenhaus-naturheilweisen.de/
Instagram: https://www.instagram.com/kfn_naturheilweisen/
LinkedIn: https://www.linkedin.com/company/krankenhaus-fuer-naturheilweisen
Disclaimer (medizinischer Hinweis):
Die bereitgestellten Inhalte dienen ausschließlich der allgemeinen Information und ersetzen keine ärztliche Untersuchung, Diagnose oder Behandlung. Treffen Sie keine gesundheitlichen Entscheidungen allein auf Grundlage dieser Aussagen. Wenn Sie Beschwerden haben oder eine Behandlung in Erwägung ziehen, besprechen Sie dies immer persönlich mit einer Ärztin, einem Arzt oder einer anderen qualifizierten medizinischen Fachperson.
Longevity ist in den letzten Jahren zu einem zentralen Thema geworden.
In der Medizin, in der Prävention, im Leistungssport und zunehmend auch im Alltag.
Dabei geht es um weit mehr als um ein langes Leben. Es geht um grundlegende Fragen zu Gesundheit, Alterung und den Faktoren, die darüber entscheiden, wie sich der Körper über Jahrzehnte entwickelt.
Gemeinsam mit Chefarzt Robert Schmidt sprechen wir darüber, warum das Thema Longevity heute so viel Aufmerksamkeit erhält, welche medizinischen und gesellschaftlichen Entwicklungen dazu geführt haben und wie Alterungsprozesse aktuell verstanden werden.
Worum geht’s in dieser Folge?
- Warum Longevity in Medizin und Gesellschaft an Bedeutung gewinnt
- Woher der Begriff stammt und wie er sich etabliert hat
- Warum Alterung lange als nicht beeinflussbar galt
- Welche Rolle Lebensstil, Umwelt und langfristige Belastungen spielen
- Warum chronische Erkrankungen oft Jahre vor dem Alter beginnen
- Weshalb das Thema nicht nur ältere Menschen betrifft
Mehr über KfN - Krankenhaus für Naturheilweisen:
Webseite: https://www.krankenhaus-naturheilweisen.de/
Instagram: https://www.instagram.com/kfn_naturheilweisen/
LinkedIn: https://www.linkedin.com/company/krankenhaus-fuer-naturheilweisen
Disclaimer (medizinischer Hinweis):
Die bereitgestellten Inhalte dienen ausschließlich der allgemeinen Information und ersetzen keine ärztliche Untersuchung, Diagnose oder Behandlung. Treffen Sie keine gesundheitlichen Entscheidungen allein auf Grundlage dieser Aussagen. Wenn Sie Beschwerden haben oder eine Behandlung in Erwägung ziehen, besprechen Sie dies immer persönlich mit einer Ärztin, einem Arzt oder einer anderen qualifizierten medizinischen Fachperson.
Post Covid ist keine einzelne Erkrankung, sondern ein komplexes Zusammenspiel mehrerer Systeme.
Energieversorgung, Immunsystem, Gefäßregulation und Nervensystem geraten aus dem Gleichgewicht.
Die Folgen können vielfältig sein und für Betroffene schwer einzuordnen.
In diesem zweiten Teil geht es um Mechanismen, Symptome und konkrete Behandlungsansätze bei Post Covid.
Gemeinsam mit Chefarzt Robert Schmidt wird erläutert, warum Post Covid als Multisystem-Erkrankung verstanden werden muss und weshalb ein individuelles, schrittweises Vorgehen entscheidend ist.
Worum geht’s in dieser Folge?
- Warum Post Covid mehrere Organsysteme gleichzeitig betrifft
- Die Rolle von Immunsystem, Entzündung und Energiestoffwechsel
- Typische Symptome von Post-Covid
- Was „Pacing“ bedeutet und warum es eine zentrale Strategie ist
- Wie Patientinnen und Patienten ihre Belastungsgrenzen erkennen können
- Welche unterstützenden Maßnahmen sinnvoll sein können
Mehr über KfN - Krankenhaus für Naturheilweisen:
Webseite: https://www.krankenhaus-naturheilweisen.de/
Instagram: https://www.instagram.com/kfn_naturheilweisen/
LinkedIn: https://www.linkedin.com/company/krankenhaus-fuer-naturheilweisen
Disclaimer (medizinischer Hinweis):
Die bereitgestellten Inhalte dienen ausschließlich der allgemeinen Information und ersetzen keine ärztliche Untersuchung, Diagnose oder Behandlung. Treffen Sie keine gesundheitlichen Entscheidungen allein auf Grundlage dieser Aussagen. Wenn Sie Beschwerden haben oder eine Behandlung in Erwägung ziehen, besprechen Sie dies immer persönlich mit einer Ärztin, einem Arzt oder einer anderen qualifizierten medizinischen Fachperson.
#podcast #gesundheit #kfn #krankenhaus #postcovid #longcovid #erkrankung #langzeitfolgen #symptome #beschwerden
Bei vielen Menschen endet eine Covid-Infektion nicht mit dem negativen Test.
Wo die akute Erkrankung vorbei ist, bleiben bei manchen Erschöpfung, Leistungsabfall oder kognitive Einschränkungen bestehen, teils über Monate oder länger.
Diese Folge beschäftigt sich mit dem Krankheitsbild Post Covid / Long Covid.
Es geht um die medizinische Einordnung, typische Symptome und die Frage, warum sich manche Menschen vollständig erholen, während andere weiterhin deutlich eingeschränkt sind.
Gemeinsam mit Chefarzt Robert Schmidt sprechen wir darüber, wie Post Covid definiert wird, wie häufig es tatsächlich auftritt und warum diese Beschwerden ernst genommen werden müssen, auch dann, wenn Standarduntersuchungen unauffällig sind.
Worum geht’s in dieser Folge?
- Definition und Abgrenzung von Post Covid und Long Covid
- Wie häufig Post Covid nach einer Infektion auftritt
- Typische Symptome
- Welche Organsysteme betroffen sein können
- Die Rolle von Nervensystem, Gefäßen und Mitochondrien
- Unterschiede zu Erschöpfungszuständen nach anderen Virusinfektionen
- Weshalb eine strukturierte Anamnese entscheidend ist
Mehr über KfN - Krankenhaus für Naturheilweisen:
Webseite: https://www.krankenhaus-naturheilweisen.de/
Instagram: https://www.instagram.com/kfn_naturheilweisen/
LinkedIn: https://www.linkedin.com/company/krankenhaus-fuer-naturheilweisen
Disclaimer (medizinischer Hinweis):
Die bereitgestellten Inhalte dienen ausschließlich der allgemeinen Information und ersetzen keine ärztliche Untersuchung, Diagnose oder Behandlung. Treffen Sie keine gesundheitlichen Entscheidungen allein auf Grundlage dieser Aussagen. Wenn Sie Beschwerden haben oder eine Behandlung in Erwägung ziehen, besprechen Sie dies immer persönlich mit einer Ärztin, einem Arzt oder einer anderen qualifizierten medizinischen Fachperson.
Viele greifen zu pflanzlichen Mitteln und wissen trotzdem nicht, was wirklich hilft.
Johanniskraut, Baldrian, Ginkgo, Teufelskralle.
Man hört davon überall: in der Apotheke, im Internet, im Freundeskreis.
Doch was davon ist sinnvoll?
Und wo kann es problematisch werden?
Es geht um pflanzliche Arzneimittel im Alltag.
Was sie leisten können. Wo sie helfen. Und wo ihre Grenzen liegen.
Gemeinsam mit Chefarzt Robert Schmidt sprechen wir darüber, bei welchen Beschwerden pflanzliche Mittel unterstützen können, worauf es bei Auswahl und Dosierung ankommt und warum „pflanzlich“ nicht automatisch harmlos bedeutet.
Worum geht’s in dieser Folge?
- Welche pflanzlichen Arzneimittel gut untersucht sind
- Johanniskraut, Teufelskralle, Weidenrinde – wann sie eingesetzt werden
- Pflanzliche Optionen bei Schmerzen und Entzündungen
- Schlafprobleme, Unruhe und innere Anspannung
- Unterschied zwischen Arzneimitteln und Nahrungsergänzung
- Warum Dosierung und Qualität entscheidend sind
- Wann pflanzliche Mittel unterstützen und wann andere Wege nötig sind
Mehr über KfN - Krankenhaus für Naturheilweisen:
Webseite: https://www.krankenhaus-naturheilweisen.de/
Instagram: https://www.instagram.com/kfn_naturheilweisen/
LinkedIn: https://www.linkedin.com/company/krankenhaus-fuer-naturheilweisen
Disclaimer (medizinischer Hinweis):
Die bereitgestellten Inhalte dienen ausschließlich der allgemeinen Information und ersetzen keine ärztliche Untersuchung, Diagnose oder Behandlung. Treffen Sie keine gesundheitlichen Entscheidungen allein auf Grundlage dieser Aussagen. Wenn Sie Beschwerden haben oder eine Behandlung in Erwägung ziehen, besprechen Sie dies immer persönlich mit einer Ärztin, einem Arzt oder einer anderen qualifizierten medizinischen Fachperson.
Unsere Gene sind kein festes Schicksal. Aber sie reagieren auf alles, was wir täglich tun.
In Teil 2 der Epigenetik-Reihe geht es um die konkreten Auswirkungen epigenetischer Prozesse auf Krankheiten und um die Frage, wie sehr wir Risiken beeinflussen können.
Gemeinsam mit Chefarzt Robert Schmidt sprechen wir darüber, welche Rolle Epigenetik bei Krebs, Diabetes, Autoimmun- und neurodegenerativen Erkrankungen spielt.
Und vor allem: Wo Prävention ansetzt, lange bevor Symptome entstehen.
Worum geht’s in dieser Folge?
- warum Epigenetik das Verbindungsglied zwischen Lebensstil und Gesundheit ist
- weshalb Krankheiten selten „plötzlich“ entstehen
- wie Ernährung, Bewegung und Stress epigenetische Muster verändern können
- welche Rolle Entzündungen, Darm und Schlaf dabei spielen
- warum Veränderungen Zeit brauchen, aber messbar sind
- wie unser Lebensstil auch kommende Generationen beeinflusst
Mehr über KfN - Krankenhaus für Naturheilweisen:
Webseite: https://www.krankenhaus-naturheilweisen.de/
Instagram: https://www.instagram.com/kfn_naturheilweisen/
LinkedIn: https://www.linkedin.com/company/krankenhaus-fuer-naturheilweisen
Disclaimer (medizinischer Hinweis):
Die bereitgestellten Inhalte dienen ausschließlich der allgemeinen Information und ersetzen keine ärztliche Untersuchung, Diagnose oder Behandlung. Treffen Sie keine gesundheitlichen Entscheidungen allein auf Grundlage dieser Aussagen. Wenn Sie Beschwerden haben oder eine Behandlung in Erwägung ziehen, besprechen Sie dies immer persönlich mit einer Ärztin, einem Arzt oder einer anderen qualifizierten medizinischen Fachperson.
Ohne Pflanzen gäbe es viele moderne Medikamente nicht.
Viele Menschen wünschen sich „etwas Pflanzliches“.
Andere vertrauen ausschließlich auf klassische Medikamente.
Doch diese Trennung greift zu kurz.
In dieser Folge geht es um das Thema Phytotherapie, die wissenschaftliche Pflanzenheilkunde.
Gemeinsam mit Chefarzt Robert Schmidt ordnen wir ein, wie pflanzliche Arzneimittel wirken, wie sie zugelassen werden und warum moderne Schulmedizin ohne pflanzliche Wirkstoffe kaum denkbar wäre.
Worum geht’s in dieser Folge?
- Was Phytotherapie wirklich ist und was nicht
- Der Unterschied zwischen Hausmitteln, traditioneller Pflanzenheilkunde und Arzneipflanzen
- Warum viele Medikamente ursprünglich aus Pflanzen stammen
- Wo pflanzliche Präparate gleichwertig wirken und wo nicht
- Warum „natürlich“ keine Garantie für Verträglichkeit ist
- und vieles mehr
Mehr über KfN - Krankenhaus für Naturheilweisen:
Webseite: https://www.krankenhaus-naturheilweisen.de/
Instagram: https://www.instagram.com/kfn_naturheilweisen/
LinkedIn: https://www.linkedin.com/company/krankenhaus-fuer-naturheilweisen
Disclaimer (medizinischer Hinweis):
Die bereitgestellten Inhalte dienen ausschließlich der allgemeinen Information und ersetzen keine ärztliche Untersuchung, Diagnose oder Behandlung. Treffen Sie keine gesundheitlichen Entscheidungen allein auf Grundlage dieser Aussagen. Wenn Sie Beschwerden haben oder eine Behandlung in Erwägung ziehst, besprechen Sie dies immer persönlich mit einer Ärztin, einem Arzt oder einer anderen qualifizierten medizinischen Fachperson.
Unsere Gene gelten als festgeschrieben.
Einmal vererbt, einmal entschieden, so die lange Annahme.
Doch die moderne Forschung zeigt ein anderes Bild.
In dieser Folge geht es um Epigenetik: Das Forschungsfeld, das erklärt, warum Gene kein starres Schicksal sind.
Worum geht’s in dieser Folge?
- Was Epigenetik ist und was sie von klassischer Genetik unterscheidet
- Warum Gene an & abgeschaltet werden können
- Wie Ernährung, Stress und Lebensstil die Genaktivität beeinflussen
- Was wir von der Natur lernen können (z. B. das Bienen-Beispiel)
- Wie epigenetische Prägung weitervererbt werden kann
- und vieles mehr
Mehr über KfN - Krankenhaus für Naturheilweisen:
Webseite: https://www.krankenhaus-naturheilweisen.de/
Instagram: https://www.instagram.com/kfn_naturheilweisen/
LinkedIn: https://www.linkedin.com/company/krankenhaus-fuer-naturheilweisen
Disclaimer (medizinischer Hinweis):
Die bereitgestellten Inhalte dienen ausschließlich der allgemeinen Information und ersetzen keine ärztliche Untersuchung, Diagnose oder Behandlung. Treffen Sie keine gesundheitlichen Entscheidungen allein auf Grundlage dieser Aussagen. Wenn Sie Beschwerden haben oder eine Behandlung in Erwägung ziehen, besprechen Sie dies immer persönlich mit einer Ärztin, einem Arzt oder einer anderen qualifizierten medizinischen Fachperson.
Stille Entzündungen verschwinden nicht durch eine Tablette.
Sie verändern sich, wenn Sie sich verändern: Schritt für Schritt, mit Gewohnheiten, die Ihren Körper entlasten statt überfordern.
Wie sprechen über:
Wie Sie nach einer Diagnose nicht in Panik geraten, sondern beginnen, Ihren Körper wieder in Balance zu bringen.
Nicht mit Radikaldiäten oder Verboten, sondern mit machbaren Veränderungen, die langfristig tragen.
Was passiert, wenn Sie wieder besser schlafen, sich mehr bewegen, Stress reduzieren und bewusster essen?
Worum geht’s in dieser Folge?
- Ersten Schritte nach der Diagnose wirklich
- Warum Schlaf, Bewegung und Ernährung die wichtigste Grundlage sind
- Wie Sie Ihren Lebensstil ehrlich analysieren
- Wie Stress Ihr Immunsystem beeinflusst
- Wie Sie mit Ernährung vorbeugen und unterstützen können
Mehr über KfN - Krankenhaus für Naturheilweisen:
Webseite: https://www.krankenhaus-naturheilweisen.de/
Instagram: https://www.instagram.com/kfn_naturheilweisen/
LinkedIn: https://www.linkedin.com/company/krankenhaus-fuer-naturheilweisen
Disclaimer (medizinischer Hinweis):
Die bereitgestellten Inhalte dienen ausschließlich der allgemeinen Information und ersetzen keine ärztliche Untersuchung, Diagnose oder Behandlung. Treffen Sie keine gesundheitlichen Entscheidungen allein auf Grundlage dieser Aussagen. Wenn Sie Beschwerden haben oder eine Behandlung in Erwägung ziehst, besprechen Sie dies immer persönlich mit einer Ärztin, einem Arzt oder einer anderen qualifizierten medizinischen Fachperson.
#podcast #gesundheit #kfn #krankenhaus #stilleentzündungen #entzündungen #silentinflamation #hilfe #ernährung #diagnose #lebensstil
Chronische Kopfschmerzen fühlen sich an, als würden sie das ganze Leben enger machen.
Nicht nur einmal im Monat, nicht nur an stressigen Tagen, sondern fast täglich, oft über Jahre hinweg.
Viele Betroffene nehmen Tabletten, funktionieren weiter, hoffen auf Besserung.
Doch Schmerzmittel lindern nur Momente und können auf Dauer sogar neue Kopfschmerzen auslösen.
In dieser Folge geht es darum, was hinter chronischen Kopfschmerzen wirklich steckt:
Wie sie entstehen, warum sie so hartnäckig sind und welche Wege es gibt, sie endlich besser zu verstehen und gezielt zu behandeln.
Worum geht’s in dieser Folge:
- Was chronische Kopfschmerzen sind und wie sie entstehen
- Welche Warnsignale Sie ernst nehmen sollten
- Die wichtigsten Auslöser: Haltung, Stress, Ernährung, Schlaf
- Erste Schritte, um die Beschwerden nachhaltig zu reduzieren
Mehr über KfN - Krankenhaus für Naturheilweisen:
Webseite: https://www.krankenhaus-naturheilweisen.de/
Instagram: https://www.instagram.com/kfn_naturheilweisen/
LinkedIn: https://www.linkedin.com/company/krankenhaus-fuer-naturheilweisen
Disclaimer (medizinischer Hinweis):
Die bereitgestellten Inhalte dienen ausschließlich der allgemeinen Information und ersetzen keine ärztliche Untersuchung, Diagnose oder Behandlung. Treffen Sie keine gesundheitlichen Entscheidungen allein auf Grundlage dieser Aussagen. Wenn Sie Beschwerden haben oder eine Behandlung in Erwägung ziehst, besprechen Sie dies immer persönlich mit einer Ärztin, einem Arzt oder einer anderen qualifizierten medizinischen Fachperson.
Stille Entzündungen passieren im Verborgenen und oft genau dort, wo wir es am wenigsten erwarten: im Schlaf, im Darm, im Nervensystem.
Während wir funktionieren, sammelt unser Körper Belastungen an: Stoffwechselreste im Gehirn, Stresshormone, Darmschlacken, entzündliche Signale.
Und viele merken es erst, wenn Energie fehlt, Schlaf kippt oder diffuse Beschwerden überhandnehmen.
In diesem Teil geht es darum, wie der Körper sich nachts reinigen sollte und warum dieser Prozess bei vielen nicht mehr richtig funktioniert.
Es geht um das glymphatische System, um Leaky Gut, um stille Immunreaktionen und um die Frage:
Wie erkennt man stille Entzündungen und was kann man wirklich dagegen tun?
Worum geht’s in dieser Folge?
- Welche Blutmarker Hinweise auf stille Entzündungen liefern
- Warum der Darm zur Eintrittspforte für Entzündung wird
- Wie chronischer Stress das Immunsystem aus dem Gleichgewicht bringt
- Erste Schritte, um Körpersysteme zu beruhigen und Entzündung zu reduzieren
Mehr über KfN - Krankenhaus für Naturheilweisen:
Webseite: https://www.krankenhaus-naturheilweisen.de/
Instagram: https://www.instagram.com/kfn_naturheilweisen/
LinkedIn: https://www.linkedin.com/company/krankenhaus-fuer-naturheilweisen
Disclaimer (medizinischer Hinweis):
Die bereitgestellten Inhalte dienen ausschließlich der allgemeinen Information und ersetzen keine ärztliche Untersuchung, Diagnose oder Behandlung. Treffen Sie keine gesundheitlichen Entscheidungen allein auf Grundlage dieser Aussagen. Wenn Sie Beschwerden haben oder eine Behandlung in Erwägung ziehst, besprechen Sie dies immer persönlich mit einer Ärztin, einem Arzt oder einer anderen qualifizierten medizinischen Fachperson.
„Stille Entzündungen tun nicht weh, aber sie können alles verändern.“
Viele Menschen fühlen sich schlapp, schlafen schlecht oder merken diffuse Beschwerden. Ohne zu ahnen, dass im Hintergrund eine stille Entzündung arbeitet.
Und das Tückische: Man spürt sie nicht. Trotzdem beeinflusst sie Stoffwechsel, Immunsystem, Energielevel und das Risiko für chronische Erkrankungen.
Woran liegt das?
In diesem Video erfahren Sie:
- wie stille Entzündungen entstehen
- warum Ernährung, Stress, viszerales Bauchfett und Darmgesundheit eine zentrale Rolle spielen
- welche Frühzeichen viele übersehen
- mit welchen Maßnahmen man gegensteuern kann
Mehr über KfN - Krankenhaus für Naturheilweisen:
Webseite: https://www.krankenhaus-naturheilweisen.de/
Instagram: https://www.instagram.com/kfn_naturheilweisen/
LinkedIn: https://www.linkedin.com/company/krankenhaus-fuer-naturheilweisen
Disclaimer (medizinischer Hinweis):
Die bereitgestellten Inhalte dienen ausschließlich der allgemeinen Information und ersetzen keine ärztliche Untersuchung, Diagnose oder Behandlung. Treffen Sie keine gesundheitlichen Entscheidungen allein auf Grundlage dieser Aussagen. Wenn Sie Beschwerden haben oder eine Behandlung in Erwägung ziehst, besprechen Sie dies immer persönlich mit einer Ärztin, einem Arzt oder einer anderen qualifizierten medizinischen Fachperson.
Die beste Medizin aus beiden Welten - wissenschaftlich fundiert, praktisch erklärt.
Chronische Schmerzen, Schlafstörungen, Entzündungen, 45% aller Deutschen leben mit chronischen Erkrankungen. Doch zwischen Schulmedizin und Naturheilkunde fühlen sich viele verloren. Genau hier setzt dieser Podcast an.
Robert Schmidt, Chefarzt der größten Klinik für integrative Medizin in Deutschland, zeigt Ihnen den dritten Weg: Evidenzbasierte integrative Medizin. Mit über 20 Jahren Praxiserfahrung und 3.000 behandelten Patienten pro Jahr teilt er, was WIRKLICH funktioniert.
Was Sie erwartet:
Studien statt Stories: Zu jedem Thema 2-3 aktuelle wissenschaftliche Studien
Praxiserfahrung: Erkenntnisse aus 110 Betten und tausenden erfolgreichen Behandlungen
Klartext ohne Dogma: Weder "nur Pillen" noch "Chemie ist Gift" – sondern das Beste aus beiden Welten
Alltagstauglich: Konkrete Protokolle und Handlungsempfehlungen für Ihre Gesundheit
Ob Diabetes Typ 2, chronische Erschöpfung, Rheuma oder Silent Inflammation wir erklären die wissenschaftlichen Mechanismen verständlich und zeigt Ihnen, wie Sie selbst aktiv werden können.
Jeden Donnerstag eine neue Episode mit echten Patientengeschichten, Expertenrunden und wissenschaftlichen Insights.
Viel Spaß beim Zuhören.
Disclaimer: Dieser Podcast ersetzt keine ärztliche Behandlung. Besprechen Sie Therapieänderungen immer mit Ihrem Arzt. Setzen Sie Medikamente niemals eigenmächtig ab.